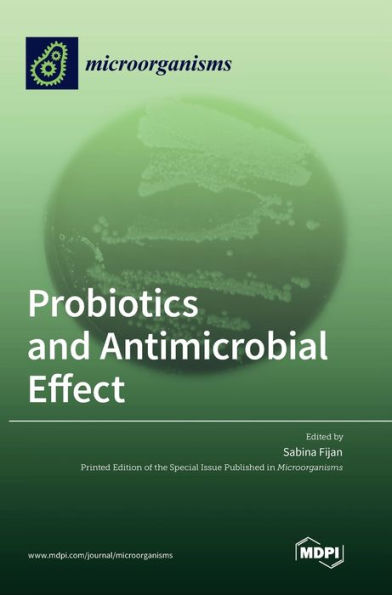
Probiotics And Antimicrobial Effect

1
/
of
1
Mdpi Ag
Probiotics And Antimicrobial Effect
Probiotics And Antimicrobial Effect
ISBN-13: 9783036569338
Regular price
$63.31
Regular price
$70.31
Sale price
$63.31
Unit price
/
per
Couldn't load pickup availability
This Special Issue of the journal Microorganisms highlights recent publications on the importance of the antimicrobial effect of probiotics. Current research is focused on finding novel or next-generation probiotic strains with antimicrobial properties that can efficiently modulate the ecological taxa composition and functionality of the human microbiota in the gut and beyond. Overall, this Special Issue has brought together new studies on the antimicrobial effects of various novel probiotics from the Weissella, Bacillus, Leuconostoc and Levilactobacillus genera, as well as well-known probiotic food supplements. It also highlights successful applications of probiotics for different infectious diseases including rotaviral gastrointestinal infections, wound infections and even COVID-19.
- | Author: Sabina Fijan
- | Publisher: Mdpi Ag
- | Publication Date: Mar 10, 2023
- | Number of Pages: 198 pages
- | Language: English
- | Binding: Hardcover
- | ISBN-10: 3036569332
- | ISBN-13: 9783036569338
Share